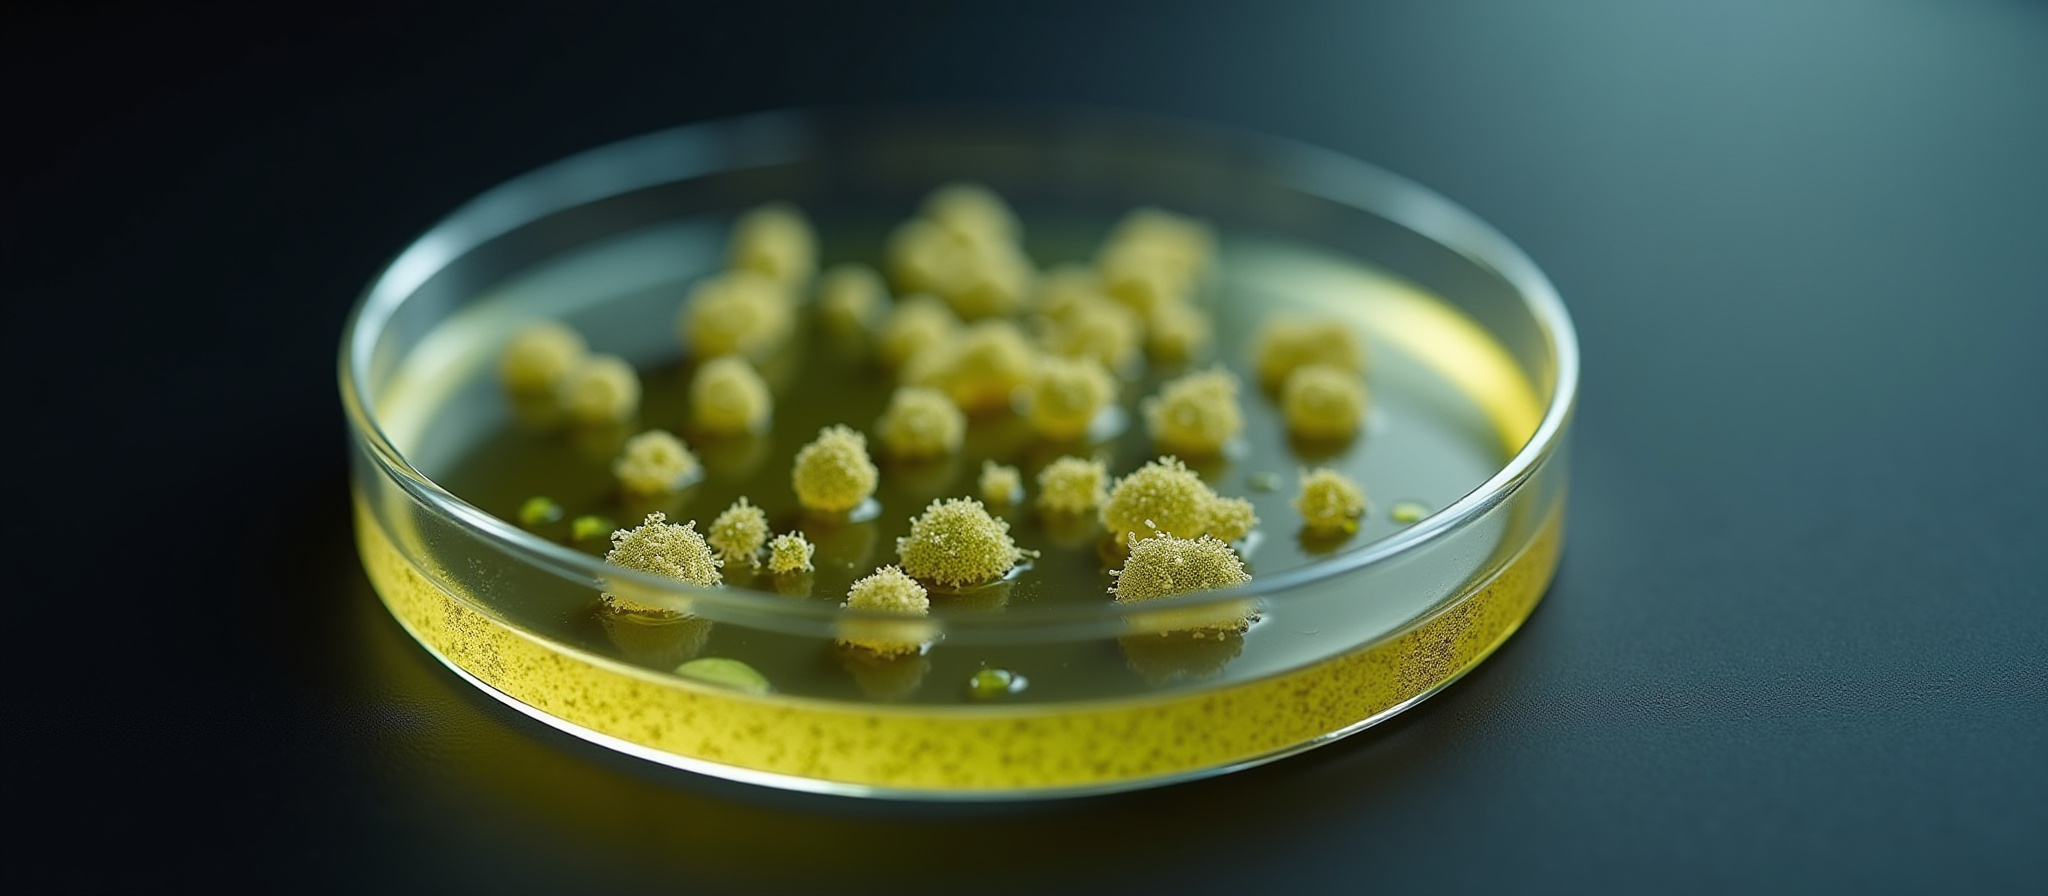

top of page
GET TO KNOW US
The Full Story
Since 2000, we have grown to become an establishment in the San Francisco area. We attribute our reputation to the lasting relationships we’ve developed throughout the years, and we pride ourselves on putting passion and dedication into everything that we do. We believe that all of our customers deserve the highest level of service, and we are committed to providing just that. Get in touch today to learn more.

bottom of page
